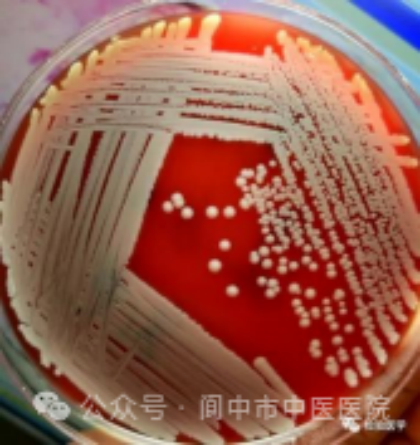
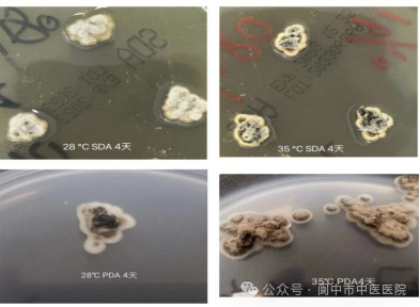

近日,在由中华医学会检验医学分会青年学组作为指导单位,检验医学传媒主办的“第四届检验与临床(感染性疾病)思维案例展示活动”中,阆中市中医医院医学检验科李春蓉、重症医学科赵艳所写的病案分析稿件《囊肺为奸 慧眼识菌明察秋毫——一例小囊菌合并肺炎克雷伯菌引起的肺部感染》在全国各级别医院共二千多稿件中经过初审、专家盲审、专家复审,层层筛选,在优中选优中脱颖而出,成功入选前50强。此稿件将会被纳入《检验与临床思维案例-感染性疾病(第四辑)》核心期刊。
作为钟南山曾经担任过会长的中华医学会,具有极高的专业性、权威性。阆中市中医医院投稿的这篇稿件在2000多篇稿件中荣进50强,是“检验与临床案例思维活动(感染性疾病)”举办以来南充地区首次进入前50强作品。

请随小编一起来看看这篇文章背后的故事:
某日重症医学科收治了一位突发语言障碍的高龄患者,经过一系列的检查,诊断为脑出血伴严重肺炎。
经验治疗无效果,炎症指标一直居高不下,病人危在旦夕,后经过检验医师与临床医生一次次的沟通与探讨,最终揪出了幕后的真凶。原来是一种罕见真菌合并高毒力细菌的感染。参阅文献发现这种罕见真菌在国内外的报道也是非常有限,给治疗增加了较大难度。
囊是指小囊菌,一种罕见的致病真菌。肺炎克雷伯菌,是一种致病细菌。让我们看看他们罕见的形态!
我们平常大家熟知的金黄色葡萄球菌是这样的:
但是小囊菌是这样的:
克雷伯球菌是这样的:

重症医学科医生迅速将情况反馈给了检验医师,检验医师立即把病菌鉴定了出来,医生根据结果调整治疗方案,最终,患者得到了对症的治疗。


成绩的取得不是偶然,这份荣誉是阆中市中医医院全体医务工作者“以人为本、爱岗敬业”的缩影,是“崇德尚学、传承创新”医院精神的生动体现,展示了阆中市中医医院医务工作者扎实的技术功底和孜孜不倦努力向上的品质。
天道酬勤,力耕不欺。从种下一粒种子到它开花,需要漫长的等待,需要我们一次次地浇水、施肥、细心看护。如果半途而废,就无法看到花朵绽放。我们引以为傲,更以此为榜样,不忘初心,砥砺深耕,在保障人民群众健康和生命安全的道路上继续勤奋耕耘,贡献自己的力量。
(责任编辑:林海南)